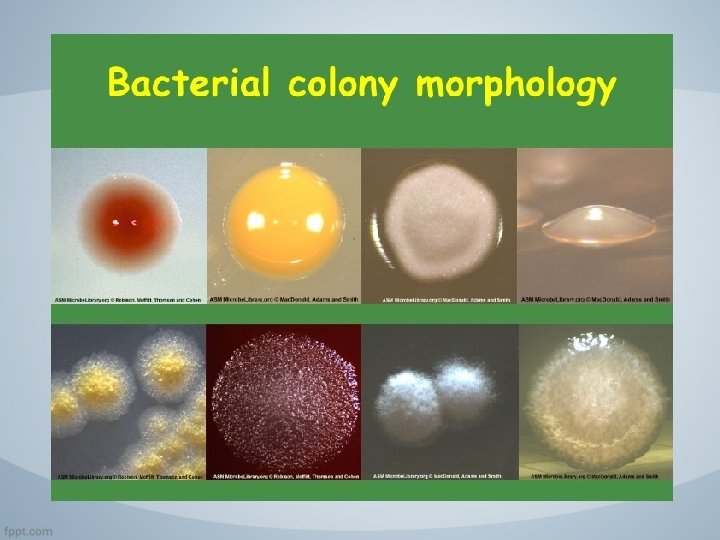

Bakteri sebagai Penyebab Penyakit Tanaman Oleh Irda Safni

Bakteri sebagai Penyebab Penyakit Tanaman Oleh: Irda Safni

Antony van Leuwenhook: first observation of bacteria 1683 2

Koch’s Postulates (1876) Pathogen is the microorganism, which : - can be isolated from the diseased organism, - can be grown in a pure culture - can infect the original host (with the original symptoms) - can be re-isolate from the new, infected host 3

Bacteria • • The smallest living organisms, Usually one cell, only few micrometer large, Shape: coccus, bacillus and spirillum Occur everywhere, constant and important constituents of biosphere 4


Big Discoveries in Bacteriology • Leuwenhook 1683 First observation of bacteria • Koch 1876: anthrax bacillus: Bacillus anthracis • Burrill 1879: Erwinia amylovora – bacteria can cause disease of plants (fire blight) • Pammel 1895: Xanthomonas campestris – from cabbage • Smith 1896: Pseudomonas solanacearum – from potato • Smith 1907: Agrobacterium tumefaciens – from fruit trees 6

1950 Zoltán Klement the pioneer of plant bacteriology in Hungary Among 1600 bacterium genera only about 300 cause diseases on plants

The Three-Domain System

Main properties of plant pathogenic bacteria • Heterotrophic organisms • Facultative parasites (usually can be cultured in pure cultures on artificial media) • Usually contains only single cells • Complex layer of cell wall • Shape: bacillus, coccus, spirillum • Majority Gram negative stained • Aerobe, seldom facultative anaerobe living style • No real nucleus, only chromatin, containing DNA • DNA containing small, round plasmids in the cytoplasm 9

Main components of the bacterial cell v. Cell membrane (lipid) v. Cell wall (double structures of phospholipids and carbohydrates) v. No independent membrane bound organelles (cell nucleus, plastids, endoplasmic reticulum)

Plasmid

Construction of bacterial cell v Complex cell wall, about 10 -20 nm thick, mucoproteid skeleton, external membranes v (Gram + and -) groups v Plant pathogenic bacteria are usually Gram -, (G+ mucoproteid skeleton is loose, or G- is compact) v Inner cytoplasm membrane, v Periplasmic space (peptidoglucane), v Outer membrane (lipids, proteins, LPSlipopolysaccharids) v Cytoplasm: ribosomes, proteins, nucleic acids, plasmids v EPS envelope (extra-cellular polysaccharide) 10

Bacterial taxons Ø Gram positive (no outer membrane) Øe. g. Actinobacteria Ø Gram negative (with outer membrane) Øe. g. Proteobacteria Ø Unknown, non classified bacteria Øe. g. Cyanobacteria

Extracellular structures • Bacterial cell wall (peptidoglucan) - Gram + type, thick, contains peptidoglucane and lipoteicnoinic acid - Gram – type thin, contains only lipopolysaccharides • Outher capsula (envelope) contains alginate and EPS (extra cellular polysaccharides)

Dinding Sel Gram Negatif & Gram Positif

Genetic material § No real, independent nucleus (prokaryotic organisms) § Irregular, round shaped DNAs in the nucleotide zone, only one giant chromosome § The genome contains about 300 genes with about 4 Mbp

Bacterial colonies § Development of colonies is characteristic for the bacteria § Emerging, round shape, slightly wave like…forms § Some are producing color substances (stains) (Corynebacterium michiganense yellow, C. insidiosum blue) 1

Environmental factors influencing the multiplication § Temperature: 2 -5 o C minimum, 25 -30 o C optimum, over 50 o C will die § Nutrients: water, carbohydrates, alkali p. H. Autotrophic and heterotrophic type of living. Aerobe and anaerobe types § Light: Not as sensitives as the animal pathogens. UV light is harmful for DNA 1

Characterisation protocol of an unknown bacterium 1. • Isolation from diseased tissue on nutrient agar • Separation of colonies • Pathogenicity experiments on tobacco plants (HR)

Characterisation protocol of an unknown bacterium 2. • Testing of bacteria producing HR on tobacco plants • Physiological and biochemical tests • Pathogenicity tests • Production of antibiotics

Characterisation protocol of an unknown bacterium 3. Pathogenicity test • On young fruits • On young sprouts • On intact plants • On cuttings

Pathogenicity of plant pathogenic bacteria v Evolution of bacteria: saprophytic, symbiontic, parasitic (P. fluorescens - P. tabaci, Agrobacterium- Rhizobacterium relationship) v Pathogenicity: toxin production, pectinases, hormones causing hypertrophy or other growth abnormalities 2

Infection conditions of phytopathogenic bacteria v Infection conditions: pathogen, susceptible plants, favourable environmental conditions v Infection by wounds and natural openings! v Starts fom the soil, through plant debrids, seeds, wounds of phloem and xyleme vessels v Vectors: insects, bees, etc. v Physiological and developmental stage of plants 2

Toxigenicity • Production and release of an extracellular microbial product that disrupts the host’s normal physiology • Proteins > exotoxins • Function away from bacterium • Potent poisons

Exotoxins vs Endotoxins Exotoxins • usually Gram +ve • extracellular • released from live cell • protein • MW 15, 000 100, 000 • Heat labile • toxoid • Antigenic > vaccine • extremely potent Endotoxins • from Gram -ve • part of cell wall • released from dead cell • lipopolysaccharide • MW millions • heat stable • no toxoid • poorly antigenic • less potent

Tahapan penting Siklus Penyakit Bakteri Tumbuhan 1. 2. 3. 4. 5. Inokulasi Penetrasi Perkembangan Infeksi Invasi Pertumbuhan dan reproduksi bakteri patogen (Kolonisasi) 6. Diseminasi bakteri patogen 7. Survival dengan ketiadaan inang

Inokulasi Yaitu: proses deposisi atau kontaknya inokulum pada permukaan jaringan inang. Inokulum : patogen yang dibawa ke tempat infeksi (bakteri) Jenis Inokulum: 1) Inokulum primer: inokulum yang bertahan dorman selama musim dingin atau musim panas dan menyebabkan infeksi pada musim semi atau musim gugur Infeksi yang ditimbulkan: “Infeksi Primer” 2) Inokulum Sekunder: Inokulum yang dihasilkan dari inokulum primer Infeksi yang ditimbulkan: “Infeksi Sekunder”

Inokulasi Sumber inokulum: Bertahan hidup (survival) pada tanaman tahunan, gulma, tanah yang terkontaminasi, sisa-sisa tanah, benih, dan vektor Kedatangan inokulum: 1. Secara pasif (mis. angin) 2. Kemotaksis – organisme di dalam tanah tertarik terhadap akar tanaman 3. Transmisi vektor (mis. serangga)

Penetrasi Yaitu: proses masuknya patogen ke dalam inang. Penetrasi aktif: patogen berpartisipasi aktif menembus dinding sel dan masuk ke dalam jaringan inang jamur, nematoda Penetrasi pasif: patogen tidak berpartisipasi aktif, dilakukan melalui luka atau lubang alami dari inang (stomata, lentisel, lubang hidatoda, dan kelenjar sekresi). bakteri

Penetrasi Patogen untuk pertumbuhan dan perkembangannya perlu makanan (nutrisi). Karena nutrisi yang dibutuhkan berada dalam jaringan inang maka untuk mendapatkannya ia harus melampaui berbagai rintangan. Patogen harus menembus (penetrate) lapisan pelindung dinding sel inang. Bahkan setelah berhasil menembus lapisan luar dinding sel, patogen masih harus menembus lapisan-lapisan lain dari dinding sel

a. Pra-penetrasi t°c p. H O 2 Rh CO 2 phylloplane Deposisi suatu inokulum di tempat infeksi sebelum penetrasi terjadi dipengaruhi oleh faktor fisik, kimia, dan biologi


Lubang alami lainnya yang berperan dalam penetrasi adalah : • Lentisel : Pectobacterium carotovorum (busuk lunak pada kentang dan wortel) • Hidatoda : Xanthomonas campestris (busuk hitam pada crucifera) masuk via tepi/ ujung helai daun. Bila. Rh rendah maka tetes air akan terhisap kembali ke dalam lubang hidatoda sekaligus membawa patogen masuk. • Trikoma : Kutikula dari kelenjar trikoma dapat pecah pada bagian sekresi kelenjar yang terakumulasi. Sobekan tersebut manjadi lubang masuk. • Sel nektar : serangga membawa inokulum dan tertinggal pada nektar yang tersisa.


Perkembangan Infeksi Yaitu: tahapan dimana patogen yang sudah menetap dalam jaringan inang mulai memperoleh nutrisi dari inangnya. ‐ Infeksi yang berhasil akan menyebabkan gejala – perubahan visual yang dapat dideteksi pada tumbuhan. ‐Patogen mengeluarkan enzim, toxksin, dan pengatur tumbuh (growth regulators). ‐Tumbuhan bereaksi dengan mekanisme pertahanan diri.

Tahap Infeksi Bakteri • • Penetrasi ke dalam jaringan intraselluler Menghindari reaksi pertahanan Merubah metabolisme inang Transfer genetik oleh plasmid (Agrobacterium) • Kolonisasi nutrisi dapat mencapai jaringan • Kolonisasi ke-dua (busuk lunak) 3

Invasi Yaitu: patogen menyebar ke seluruh tanaman. § Bakteri menyebar dengan pertumbuhan intraseluler dengan menggunakan enzim, dan hormon dan secara lokal.

Pertumbuhan dan Reproduksi Bakteri Patogen (Kolonisasi) v Patogen terus menyebar sampai infeksi berhenti dan tumbuhan mati. v Hanya jamur dan nematoda yang dapat aktif bergerak, sedangkan patogen lain seperti bakteri bereproduksi dengan cepat dan bergerak secara pasif. v Bakteri bergerak secara intraseluler. Saat sel yang terinfeksi terbelah dua maka sebagian sel yang berasosiasi ditransfer ke sel yang baru. Banyak bakteri yang melakukan multiplikasi di dalam sistem pembuluh xylem.


Diseminasi Patogen Struktur patogen yang berfungsi sebagai inokulum (sekunder) disebarkan/ didiseminasikan oleh serangga, air, angin atau agen penyebar yang lain.

Penyebaran inokulum • Angin • Air/ hujan take off, flight, deposisi. memindahkan spora dan mengaktifkan metabolisme. • Serangga (sebagai vektor) terbawa pada tubuh/ organ pemotong. • Benih atau pun bagian lain virus/ viroid, bakteri, cendawan. • Manusia jarak jauh. Lingkungan yang ekstrim …. . ? ******** ******** ******* ******* Iklim temperate (subtropik) patogen harus mampu bertahan pada kondisi ekstrim.

Survival Bakteri dengan Ketiadaan Inang Fungi Bacteria Viruses Nematodes Survival Crop residue Soil Alt. hosts ‐ Crop residue Soil Alt. hosts Insect vectors ‐ ‐ Alt. hosts Insect vectors Crop residue Soil ‐ ‐ Dispersal Wind Rain Insects ‐ ‐ Insects Tillage Equipment Water run‐off Infection Directly ‐ Wounds Insect feeding ‐ ‐ Insect feeding Directly ‐ ‐

Gejala Penyakit Bakteri Tumbuhan

Gejala penyakit dapat diklasifikasikan menjadi 3, yaitu: 1. Gejala Lokal / Sistemik 2. Gejala Primer / Sekunder 3. Gejala Mikroskopik / Makroskopik

v. Gejala lokal: Perubahan fisiologi atau struktural pada area yang terbatas pada jaringan tanaman inang di sekitar tempat infeksi. Cth. Becak daun, bintal dan kanker. v Gejala Sistemik termasuk reaksi bagian besar seluruh tanaman. Cth. Layu, gejala menguning, dan kerdil.

ØGejala Primer: hasil aktivitas langsung patogen pada jaringan yang diinfeksi. Cth. Bengkak ― pada kubis (clubroot of cabbage) dan “bintal“ yang dibentuk dari aktivitas memakan nematoda puru akar. ØGejala Sekunder: hasil dari efek fisiologi penyakit pada jaringan yang jauh dan organ yang tidak diinfeksi. Cth. Layu dan gugurnya daun tanaman buncis pada waktu udara panas akibat dari busuk akar Fusarium atau nematoda puru akar.

Gejala Utama yang disebabkan Infeksi Bakteri • Becak daun, nekrosis lokal (Pseudomonas, Xanthomonas) • Canker , luka (Pseudomonas syringae, Erwinia amlylovora) • Layu (irreversible and reversible) (Ralstonia solanacearum) • Busuk lunak umbi (Tuber soft rot) (Pectobacterium carotovorum) • Tumor (Agrobacterium tumefaciens) • Kudis (Scab) (Streptomyces scabies) 4

Nekrosis Adalah gejala lokal atau kematian umum/degenerasi jaringan tanaman (protoplas). Contoh. Becak daun, hawar, busuk, dll. Nekrosis pada tembakau yang disebabkan oleh Pseudomonas syringae pv. tabaci

Beberapa gejala nekrosis Layu (wilting): § Kehilangan tekanan turgor pada tanaman yang menyebabkan tanaman menggugurkan daun atau seluruh tanaman untuk sementara atau permanen dari kekurangan air atau infeksi patogen yang berbeda. § Biasanya gejala kedua karena terhambatnya jaringan xilem oleh suatu organisme (ring necrosis). Contoh: • Layu Ralstonia solanacearum • Curtobacterium flaccumfaciens, P. syringae pv. phaseolicola, Xanthomonas campestris pv. phaseoli

Arus Bakteri di dalam air ketika batang yang terinfeksi dipotong dan ditempatkan di dalam air akan mengeluarkan lendir putih seperti benang-benang yang dapat diamati selama 15 menit. Lendir ini adalah ooze bakteri.

Layu yang disebabkan penghambatan pembuluh Ralstonia solanaceraum menghambat sistem pembuluh dan menyebabkan layu sementara tanaman kentang dan nekrosis cincin (ring necrosis) padaumbi.

Penyakit Darah Pisang (Banana Blood Disease)

Becak § luka lokal berbentuk bulat, biasanya dikelilingi warna yang berbeda § ciri-ciri: pada tempat becak (becak daun, becak buah) dan warna (becak coklat, becak hitam) § Jika becak membesar dan bersatu, dapat berkembang menjadi becak tidak beraturan dan hawar, seperti becak daun tomat, becak hitak bunga mawar, becak daun dengan halo kuning, becak buah, dll.

Water-soaking (Hydrosis): Kondisi jaringan tanaman menjadi tembus cahaya yang disebabkan pergerakan air dari sel inang karena terputusnya membran sel menuju ke ruang interseluler. Contoh. Luka hawar pada daun kentang dan tomat; busuk lunak pada sayuran berdaging.

Water soaking and necrosis (Pseudomonas syringae pv. phaseolicola) Photo: S. Kadlicskó 5

Septoria leaf spot of tomato plant caused by Septoria lycopersici

Hawar (Blight) § Perubahan warna secara mendadak dan pembunuhan daerah daun, batang atau seluruh tanaman secara luas. § Biasanya jaringan tanaman yang muda yang diserang. § Nama penyakit biasanya diikuti oleh nama inangnya dan bagian yang diserang, cth. blossom blight, twig blight, tip blight

Gejala hawar daun (fire blight) pada pir yang disebabkan oleh Erwinia amylovora

Bacterial blight of rice caused by Xanthomonas campestris p. v. oryzae A healthy rice crop

Rice blast lesions on rice leaves Collar-rot symptoms of rice blast Panicle blast of rice caused by Magnaporthe oryzae Rice seed infected by blast showing symptoms of brown blotches

Mati pucuk (Dieback) Perubahan warna menjadi coklat secara progressif dan kematian daun, batang, dan akar, dimulai dari ujung hingga ke bawah Cth. Die back of chilli/ citrus Die back of citrus caused by motile bacteria, Candidatus Liberibacter spp (Liberobacter asiaticum, Liberobacter africanum)

Busuk lunak (Soft rot) § Penyakit yang disebabkan patogen yang mengeluarkan enzim yang mampu mendekomposisi struktur dinding sel, sehingga menghancurkan tekstur jaringan tanaman. § Jaringan tanaman menjadi lembek (lunak dan berair). • Enzim Pektolitik (pectinases, pectin metylesterases) berperan membusukkan lisate the tuber tissues • Pathogenicity depends on the enzyme activities § Busuk lunak umum terjadi pada tanaman sayiran yang berdaging, seperti kentang, wortel, Capsicum, labu dan tomat.

Busuk lunak wortel yang disebabkan Pectobacterium carotovorum Fotos: T. Vigh 6

Potato soft rot (Pectobacterium carotovorum) 6

Soft rot symptoms on Capsicum caused by Pectobacterium carotovorum subsp. Atroseptica Soft rot symptoms on Avocado caused by Erwinia herbicola

Busuk Hitam (Black rot) tanaman Crucifera yang disebabkan oleh Xanthomonas campestris p. v. campestris, juga penyakit bakteri di mana sistem vaskularnya daun. terinfeksi dan menyebabkan nekrosis

Symptoms of black rot on cabbage transplants V-shaped lesions on mature cabbage Discoloured vascular tissue in cabbage stem due to black rot caused by Xanthomonas campestris p. v campestris

Becak Bergaris: sempit, memanjang, paralel, luka nekrosis Cth. Red stripe of sugarcane caused by Pseudomonas rubrilineans Red stripe of sugarcane on leaves Pseudomonas rubrilineans

HIPOPLASTIS Hipoplasia: kegagalan tanaman atau organ untuk berkembang penuh, misalnya untuk mendapat ukuran normal. Ukuran abnormal dan perubahan warna menjadi pucat adalah gejala hipolastis paling umum. HIPERPLASTIS Hyperplasia: perkembangan yang berlebihan (dalam ukuran dan warna) dari bagian tanaman. Hypertrophy: perkembangan eksklusif organ tanaman karena over hyperplasia. Contoh: Daun keriting – jaringan yang tumbuh berlebihan pada satu sisi daun atau bunga menyebabkan daun menggulung.

Kudis (Scabs): kulit yang mengeras hingga seperti berkarat, lebih kurang berbentuk bulat, luka yang mengeriput pada permukaan daun, batang, buah, atau umbi. Contoh. common scab of potato, apple scab and wheat scab. Potato scab caused by Streptomyces scabies

Tumor: § Gejala yang disebabkan patogen yang menstimulasi pembelahan sel tanaman yang tidak dapat dikendalikan yang menyebabkan pembentukan struktur abnormal yang besar. § Pembelahan sel dan jaringan pada tumbuhan dikoltil dengan mentransfer plasmid DNA bakteri.


Tumors on olive trees (Pseudomonas savastanoi) 7

Terima Kasih
- Slides: 75